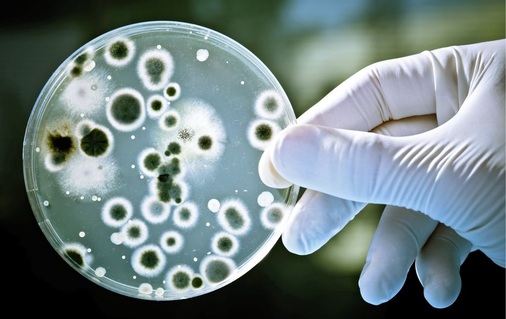
Der Nachweis: Auf dem Nährboden haben sich Bakterienkolonien (KBE) gebildet, die gezählt werden können.

Während der Anfänge der Trinkwassererwärmung waren Fragen der Hygiene kein Thema. Wenn nicht der Topf auf dem Ofen samstags dafür herhalten musste, dann war es vielleicht der klassische Kohlebadeofen, in dem das Wasser unmittelbar vor Gebrauch erwärmt und dann genutzt wurde. Danach kühlte es wieder auf kühle Raumtemperatur ab. Und Wasserstrahlen gab’s aus einer Brause mit 15 Löchern, die eine feine Wasserverneblung, sprich Aerosolbildung, gar nicht erst aufkommen ließ.
Gefährlicher Komfort
Die temporäre Erwärmung auf meist hohe Temperaturen gab einer Bakterienvermehrung kaum eine Chance. Und die paar Exemplare von Bazilli, die es schafften, in diesem Wasser aktiv zu bleiben, genügten an Menge und Verteilung nicht mehr, um dem Nutzer gefährlich zu werden. Wachsende Komfortansprüche und der Wunsch nach Energieeinsparung änderten diese Situation in den 70er-Jahren des vergangenen Jahrhunderts drastisch.
Zum einen sollte warmes Wasser ständig zur Verfügung stehen. Zum anderen sollten die Bereitschaftsverluste dabei so gering wie möglich gehalten werden. Speicher-Wassererwärmer mit Wassertemperaturen von 60°C oder mehr zu betreiben, erschien wirtschaftlich als nicht sinnvoll – denn wer benötigt schon so heißes Wasser? Und so pendelten sich die Betriebstemperaturen um die 40 bis 45°C ein. Was energetisch durchaus sinnvoll ist, wurde auch von den Bakterien begrüßt; sie bekamen mit dem warmen Wasser einen Lebensraum bereitgestellt.
Gleichzeitig sollte auch die einfache 15-Loch-Brause ausgedient haben. Was nun gefragt war, waren Duschen, die durch einige verschiedene Strahlarten begeistern sollten. Technik musste dafür her, die eine Entleerung der Brause (bedingt durch die Stauscheiben zur Strahlbildung) nicht mehr möglich machte und zudem auch Wasser unter Bildung von Aerosol austreten ließ. Die Bakterien aus dem Speicher fanden somit ihren Weg zum (oder besser: in den) Menschen. Hieraus resultierende Erkrankungen und sogar Todesfälle konnte man aber nicht mit der Warmwasser-Installation in Verbindung bringen.
Bakterien in Philadelphia
Im Jahre 1976 wurden in einer Klimaanlage eines Hotels in Philadelphia Bakterien entdeckt, die eine der Lungenentzündung zunächst ähnliche Erkrankung auslösen. Erwischt hatte es damals die Teilnehmer eines Treffens von Veteranen der amerikanischen Fremdenlegion. Zahlreiche Teilnehmer starben an der Erkrankung. Später wurden Vertreter dieser neu entdeckten Bakteriengattung auch in Warmwassersystemen von Gebäuden gefunden. Da das „Kind“ einen Namen brauchte und die ersten zuordnungsfähigen Opfer die Legionäre waren, hatte dieser Erreger schnell seinen umgangssprachlichen Namen weg: Legionelle.
Bei den Legionellen handelt es sich um stäbchenförmige Bakterien, die Wasser als Lebensraum nutzen. Sie kommen in allen Süßwässern vor, in Seen, Flüssen oder gar Pfützen. Sie sind folglich ein natürlicher Bestandteil des Wassers. Man unterscheidet heute mehr als 35 verschiedene Arten dieser Bakteriengattung mit 50 Untergruppen. Die Mehrzahl dieser Arten kann beim Menschen Erkrankungen auslösen, wenn sie in entsprechender Anzahl auf ihn treffen. Als besonders gefährlich kann dabei die Legionella pneumophilla Serogruppe 1 Subtyp Pontiac bezeichnet werden. Auf ihr Konto gingen auch die erkrankten und toten Legionäre in Philadelphia.
Optimal bis tödlich
Optimale Lebensbedingungen für Legionellen sind Wassertemperaturen zwischen mehr als 25°C und 45°C sowie Bereiche mit geringer oder keiner Wasserströmung. Unter solchen Bedingungen liegt die Teilungsrate der Legionellen deutlich über der Sterberate, was die Anzahl der Legionellen im Wasser erhöht, im Temperaturbereich von 30°C bis 45°C sogar drastisch. Eine bislang harmlose Legionellen-Bevölkerung kann so schnell zu einem Problem werden. Dabei sind die „Legios“ in Sachen Vermehrung eher Teilungsmuffel. Um ihre Anzahl zu verdoppeln, benötigen sie unter den beschriebenen optimalen Bedingungen etwa drei Stunden – andere Bakterien erledigen das ganz locker in rund 30 Minuten. Der Grad des Befalls eines Wassers wird in Koloniebildenden Einheiten, kurz KBE, angegeben. Um diese festzustellen, wird eine Wasserprobe (beispielsweise 1 ml) auf einen Nährboden gegeben und anschließend für 36 Stunden in einem Wärmeschrank bei 42°C verwahrt. Unter diesen optimalen Bedingungen entstehen mit bloßem Auge sichtbare Bakterienkolonien. Sind z.B. zehn Kolonien entstanden, spricht man von einem Wasser mit 10 KBE Legionellen in einem Milliliter (10/1ml).
Die Temperatur ist der Schlüssel, um den Legionellen das Leben schwer bis unmöglich zu machen. Wasser mit mehr als 50°C mögen sie weniger, in 60 Grad heißem Wasser überleben sie nur rund ein bis zwei Stunden, Wasser mit 70°C tötet sie im Normalfall innerhalb von etwa drei Minuten. Dieser Normalfall beschreibt eine frei im Wasser befindliche Legionelle. Allerdings haben Legionellen auch Möglichkeiten gefunden, sich zu hohen Temperaturen zu entziehen. So verstecken sie sich vor zu großer Hitze im Biofilm, der sich auf Rohr- und Behälterwandungen befinden kann, oder dringen in Ablagerungen ein. Einen Schutz bieten auch Amöben. Amöben umfließen ihre Nahrung für gewöhnlich, um diese dann zu verwerten. Die Legionellen lassen sich das auch gefallen, sind für Amöben aber ein unverdaulicher Happen, da die Verdauungsenzyme der Amöben den Legionellen nichts anhaben können. So dient die Amöbe der Legionelle als Schutz. Daher kann man folglich nicht grundsätzlich annehmen, dass Wasser mit 70°C frei von (lebenden) Legionellen ist.
Hinzu kommt das Siedlungsverhalten von Legionellen. Zunächst hatte man angenommen, dass diese Bakterien grundsätzlich im Wasser schwimmen. Tatsächlich aber leben sie bevorzugt in Biofilmen. Nur dann, wenn dieser Siedlungsraum zu voll wird, gehen sie mit dem Wasser auf die Reise und suchen neue Lebensbereiche. Es kann also durchaus vorkommen, dass Wasser an dem einen Tag einen nennenswerten KBE-Wert mit sich trägt, an einem anderen Tag aber (scheinbar) legionellenfrei ist.
Gefährlicher Lungenkiller
Dem Nutzer der Trinkwasser-Installation gefährlich werden die Legionellen, wenn es sich um eine krank machende Art handelt und diese in einer entsprechenden Anzahl im Wasser vorhanden ist. Wie groß die Anzahl der KBE sein muss, um eine Erkrankung auszulösen, kann nicht pauschal gesagt werden. Es hängt hier zu viel von der persönlichen Verfassung des Benutzers der Anlage ab. Ein kerngesunder, vitaler Mensch ist logischerweise weniger gefährdet als jemand, der schon mit einer Krankheit zu kämpfen hat oder durch einen medizinischen Eingriff geschwächt ist. Die Erfahrung zeigt aber, dass ein Befund unter 100 KBE kein Anlass für Bedenken sein muss.
Die Legionellen gelangen hauptsächlich mit dem Wasserdampf, der beispielsweise beim Duschen entsteht, durch einatmen in den Körper. Eine Aufnahme von Legionellen über offene Wunden ist auch möglich, kommt jedoch recht selten vor. Einmal aufgenommen, können die Legionellen zu einer Erkrankung an Pontiac-Fieber oder an Legionellenpneumonie (auch Legionellose oder Legionärskrankheit genannt) führen. Im harmloseren Fall handelt man sich das Pontiac-Fieber ein, benannt nach der Stadt Pontiac im US-Bundesstaat Michigan, in der die erste Epidemie dieser Krankheit auftrat. Etwa zwei Tage nach der Infektion treten dabei der Grippe ähnliche Symptome (Fieber, Kopfschmerzen, Schüttelfrost etc.) auf, die aber nach ein paar Tagen Bettruhe von selbst und ohne ärztliche Behandlung wieder abklingen. Von einem tödlichen Verlauf des Pontiac-Fiebers ist nichts bekannt. Man vermutet, dass viele Menschen diese Krankheit schon einmal hatten, sie aber als schwere Erkältung oder Grippe – und nicht als durch Legionellen verursachte Erkrankung – wahrgenommen haben.
Anders sieht das allerdings im Falle einer Legionellenpneumonie aus. Diese in Deutschland meldepflichtige Erkrankung hat unbehandelt einen meist tödlichen Verlauf. Und auch bei stationärer professioneller medizinischer Versorgung sterben rund 15 % der Patienten daran; bei den bereits vorab gesundheitlich geschwächten Patienten (z.B. nach einer Operation oder Personen mit weiteren Krankheiten) beträgt die Chance zu überleben nur rund 30 %. Etwa zwei bis zehn Tage nach der Kontamination treten zunächst Symptome auf, die dem Pontiac-Fieber sehr ähnlich sind. Schnell kommen dann sehr hohes Fieber, Muskelschmerzen, Schmerzen im Brustkorb und Reizhusten dazu. Im Endstadium kommt es zu Durchfall, Erbrechen, Atemnot und Verwirrtheit. Wenn es denn ein schönes Ende gibt, gehört diese Art des Abtretens also keinesfalls dazu.
Gesetzgeber greift ein
Schon deshalb sieht auch der Gesetzgeber Bedarf, hier regelnd einzugreifen, um das Risiko soweit wie möglich zu reduzieren. Bislang war es (nur) eine vertragliche Pflicht eines Vermieters (§ 536 Bürgerliches Gesetzbuch, BGB) dafür zu sorgen, dass seine zentrale Trinkwassererwärmungsanlage sauber, also frei von Legionellen ist. Mit der neuen Trinkwasserverordnung ist eine exorbitante Anzahl von Hausbesitzern nunmehr seit dem 1. November 2011 gesetzlich verpflichtet, ihre Installation jährlich einmal hinsichtlich einer möglichen Legionellen-Kontamination untersuchen zu lassen. Das gilt für gewerblich genutzte Großanlagen der Wassererwärmung, bei denen bei der Wasserentnahme eine Aerosolbildung nicht ausgeschlossen werden kann. Was hier mehr in Richtung Industrieanlage klingt, gilt aber tatsächlich für viele Wohngebäude.
Nach der Definition der neuen Trinkwasserverordnung gilt die Installation in einem Mietshaus als gewerblich genutzt, da die Anlage mit der Wohnung vermietet und damit also Geld verdient wird. Hat der Trinkwassererwärmer des Hauses dann noch mehr als 400 Liter Inhalt bzw. beträgt der Leitungsinhalt zwischen Speicher und einer beliebigen Entnahmestelle im Haus mehr als drei Liter, liegt eine Großanlage im Sinne der technischen Regeln (DVGW W 551) vor. Werden im Hause dann noch aerosolbildende Entnahmestellen betrieben – also eine Brause – ist die Pflicht zur regelmäßigen Überprüfung gegeben. Ergeben die Kontrollen in drei aufeinander folgenden Jahren ein einwandfreies Ergebnis, darf das Gesundheitsamt den Überwachungsturnus innerhalb eines Drei-Jahres-Zeitraumes länger fassen.
Von vier Wochen bis drei Jahre
Während sich die einwandfreie Installation mit der Zeit auf diese Kontrollerleichterung berufen kann, müssen an legionellentechnisch mangelhaften Anlagen Maßnahmen erfolgen. Welcher Handlungsbedarf innerhalb welchen Zeitraumes besteht, hängt vom Umfang der Kontamination ab. Hier wird nach geringer, mittlerer, hoher und extrem hoher Kontamination unterschieden.
Bei einer festgestellten geringen Kontamination (< 100 KBE/100 ml) sind keine Maßnahmen nötig. Eine mittlere Kontamination (> 100 KBE/100 ml und < 1000 KBE/100 ml) muss innerhalb eines Jahres eine Sanierung des Systems erfolgen. Eine hohe Kontamination (> 1000 KBE/100 ml und < 10000 KBE/ 100ml) macht eine Abhilfe innerhalb von drei Monaten nötig, bei extrem hoher Kontamination (> 10000 KBE/100 ml) muss sofort etwas passieren. Ferner ist es unter Umständen nötig, Nutzungseinschränkungen (z.B. ein Duschverbot) zu formulieren.
Ziel einer Sanierung ist es, die Ursachen für den Legionellenbefall abzustellen. Dazu kann ein entsprechender Umbau der Installation nötig sein. Um diese Maßnahmen gezielt zu planen, muss der Bewertung der Installation eine Anlagendokumentation zugrunde liegen. Das ist eine vom Planer erstellte Unterlage, die Auskunft gibt über verarbeitete Materialien, Dämmungen, geplante Betriebstemperaturen etc. Sie gehört zu den Papieren (bzw. Datensätzen), die dem Betreiber im Rahmen der Übergabe einer Installation übergeben werden müssen. Der damit mögliche Soll-Ist-Vergleich hilft dann mit, die Ursache für den gefährlichen Bakterienbefall möglichst genau auszumachen – damit niemand, der duscht, dabei ungewollt russisches Roulette spielen muss.
INFO
Regelung im BGB
Der Vermieter hat gemäß § 536 BGB die vermietete Sache dem Mieter in einem zu dem vertragsmäßigen Gebrauche geeigneten Zustande zu überlassen und sie während der Mietzeit in diesem Zustande zu erhalten.
zur Sache
Haftung bei Kontamination
Grundeigentümer, die Vermieter bzw. Betreiber einer Gewerbeimmobilie sind, müssen Schadensersatz und Schmerzensgeld zahlen, wenn jemand durch technische Mängel in dem Gebäude geschädigt wird. Wenn nicht alle notwendigen Sicherheitsvorkehrungen getroffen werden, um andere Personen vor Schaden zu bewahren, besteht das Risiko einer unbeschränkten Haftung. Rechtsgrundlage ist ein Urteil des Landgerichts Dortmund (1.9.2010 – 4 O 167/09), das Grundeigentümer zur Erstattung von Schadensersatz und Schmerzensgeld verpflichtet. Ausgangspunkt ist der Fall einer Frau, die im Rahmen einer Untersuchung die Dusche in den Räumen einer Arztpraxis benutzte. Wenige Tage später wurde sie wegen einer Infektion mit Legionellen in eine Notfallklinik eingeliefert und dort langwierig behandelt. Daraufhin verklagte sie u.a. den Grundstückseigentümer als Betreiber der Immobilie auf Schadensersatz. Sie argumentierte, dass der Gebäudeeigentümer für die Installation, Einrichtung und Wartung der Heizungsanlage verantwortlich sei.
Quelle: Lill Rechtsanwälte, Berlin
Checkliste
Inhalte einer Anlagen-Dokumentation
System der Wassererwärmung / Art der Warmwasserbevorratung
Maßnahmen der Wasserbehandlung
Anlagentemperaturen (TW / TWW / TWZ)
Leitungsverlauf
Nennweiten
Rohrwerkstoff
Dämmstoffe (Material, Wärmedurchlasskoeffizient, Dämmstoffdicke)
Armaturen
Probenahmemöglichkeiten
Sicherungsarmaturen
Sicherheits- und Regelarmaturen